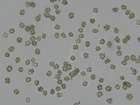
Mikromerkmale

Verwandte Arten
Hydnellum aurantiacum (Batsch : Fr.) P. Karst. emend. Otto 1879
Hydnellum aurantiacum (Batsch) P. Karst. 1879 ss. Maas Geest.
Hydnellum auratile (Britzelm.) Maas Geest. 1959
Hydnellum caeruleum (Hornem.) P. Karst. 1879
Hydnellum coalitum Maas Geest. 1975
Hydnellum compactum (Pers.) P. Karst. 1879
Hydnellum concrescens agg.
Hydnellum concrescens (Pers.) Banker 1906 s. str.
Hydnellum cumulatum Harrison 1964
Hydnellum cyaneotinctum (Peck) Banker 1906
Hydnellum diabolus Banker 1913
Hydnellum fagiscabrosum A.M. Ainsw. & Nitare 2021
Hydnellum ferrugineum (Fr.) P. Karst. 1879
Hydnellum ferrugipes Coker 1919
Hydnellum floriforme (Schaeff.) Banker 1906
Hydnellum geogenium (Fr.) Banker 1913
Hydnellum gracilipes (P. Karst.) P. Karst. 1879
Hydnellum mirabile (Fr.) P. Karst. 1879
Hydnellum peckii Banker 1912
Hydnellum scabrosum (Fr.) E. Larss., K.H. Larss. & Kõljalg 2019
Hydnellum scrobiculatum (Fr.) P. Karst. 1879
Hydnellum spongiosipes (Peck) Pouzar 1960
Hydnellum suaveolens (Scop.) P. Karst. 1879
Hydnellum tardum Maas Geest. 1975
Hydnellum aurantiacum (Batsch) P. Karst. 1879 ss. Maas Geest.
Hydnellum auratile (Britzelm.) Maas Geest. 1959
Hydnellum caeruleum (Hornem.) P. Karst. 1879
Hydnellum coalitum Maas Geest. 1975
Hydnellum compactum (Pers.) P. Karst. 1879
Hydnellum concrescens agg.
Hydnellum concrescens (Pers.) Banker 1906 s. str.
Hydnellum cumulatum Harrison 1964
Hydnellum cyaneotinctum (Peck) Banker 1906
Hydnellum diabolus Banker 1913
Hydnellum fagiscabrosum A.M. Ainsw. & Nitare 2021
Hydnellum ferrugineum (Fr.) P. Karst. 1879
Hydnellum ferrugipes Coker 1919
Hydnellum floriforme (Schaeff.) Banker 1906
Hydnellum geogenium (Fr.) Banker 1913
Hydnellum gracilipes (P. Karst.) P. Karst. 1879
Hydnellum mirabile (Fr.) P. Karst. 1879
Hydnellum peckii Banker 1912
Hydnellum scabrosum (Fr.) E. Larss., K.H. Larss. & Kõljalg 2019
Hydnellum scrobiculatum (Fr.) P. Karst. 1879
Hydnellum spongiosipes (Peck) Pouzar 1960
Hydnellum suaveolens (Scop.) P. Karst. 1879
Hydnellum tardum Maas Geest. 1975

Bitte wechseln Sie zu einem Bundesland, um detailliertere Darstellungen für einzelne Fundstellen einzusehen oder eine genauere Karte zur Weiterverwendung zu beziehen.
Hydnellum concrescens agg.
Synonyme: Calodon zonatus (Batsch) P. Karst. 1882, Hydnum concrescens Pers. 1796, Hydnum zonatum Batsch 1783
Systematik: Basidiomycota > Thelephorales > Thelephoraceae
Deutscher Name: Gezonter Korkstacheling
Bitte registrieren Sie sich kostenlos auf den Seiten, damit Sie auf alle Informationen und Fundstellendaten zu den Arten Zugriff erhalten und die volle Funktionalität der internetseite nutzen können: